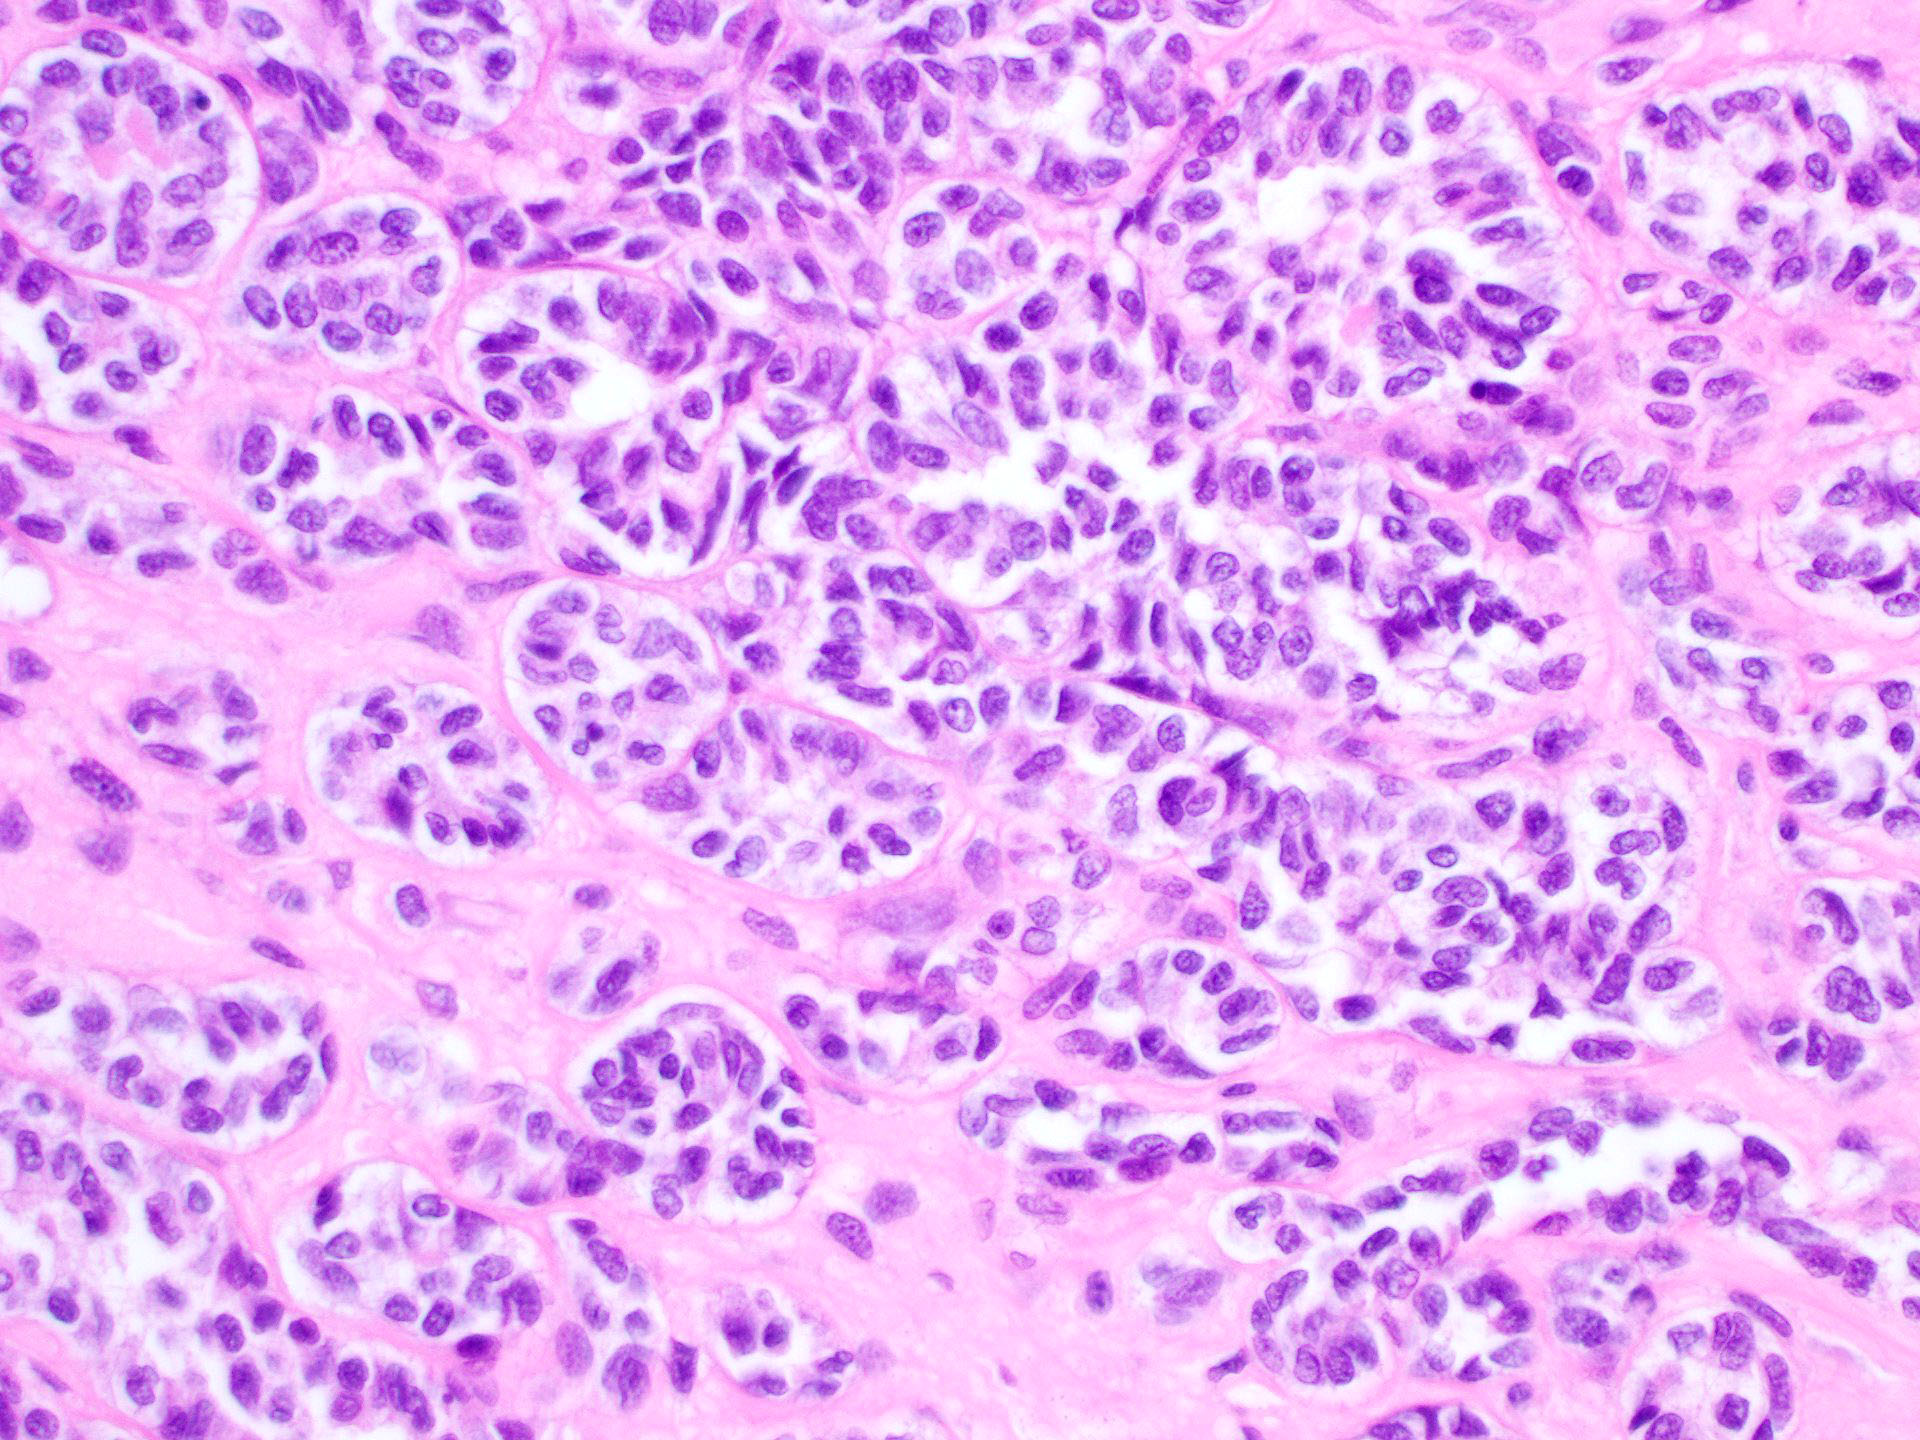

Table of Contents
Definition / general | Essential features | ICD coding | Epidemiology | Sites | Pathophysiology | Etiology | Diagrams / tables | Clinical features | Diagnosis | Laboratory | Radiology description | Prognostic factors | Case reports | Treatment | Gross description | Gross images | Frozen section description | Microscopic (histologic) description | Microscopic (histologic) images | Positive stains | Negative stains | Molecular / cytogenetics description | Sample pathology report | Differential diagnosis | Additional references | Practice question #1 | Practice answer #1Cite this page: Welter SM, Khalifa MA. Sertoli cell tumor. PathologyOutlines.com website. https://www.pathologyoutlines.com/topic/ovarytumorsertoli.html. Accessed September 18th, 2025.
Definition / general
- Pure sex cord neoplasm of the ovary composed of Sertoli cells most commonly arranged in a tubular pattern
- Rare to no Leydig cells present
- Many have hormone manifestations (most commonly estrogenic)
Essential features
- Solid or hollow tubules with or without other histologic patterns containing cuboidal cells that are positive for sex cord markers
ICD coding
- ICD-O: 8640/1 - Sertoli cell tumor, NOS
- ICD-11: 2F32.Z & XH4H24 - benign neoplasm of ovary, unspecified & Sertoli cell tumor, NOS
Epidemiology
- Rare tumor
- Occurs at any age (mean: 30) (Am J Surg Pathol 2005;29:143)
Sites
- Ovary
Pathophysiology
- Subset have DICER1 mutation (Mod Pathol 2015;28:1603)
Etiology
- No known causative agents
Clinical features
- Incidental finding or may present with signs and symptoms of pelvic mass
- Hormonal manifestations
- Most commonly due to estrogen
- Less commonly due to production of androgens, renin, progesterone or aldosterone
- Associations
- Peutz-Jeghers syndrome (lipid rich and oxyphilic variants) (Int J Surg Pathol 2016;24:269)
- DICER mutation
- Reference: Cancer 1980;46:2281
Diagnosis
- Tumor can be identified via ultrasound or other imaging studies
- Removal of the ovary is then needed for histologic evaluation
Laboratory
- Generally not useful although hormonal manifestations are seen and suggest a possible steroid producing tumor
Radiology description
- Predominantly solid mass in the ovarian parenchyma
Prognostic factors
- Excellent in the vast majority of cases
- Features of malignancy
- Severe cytologic atypia
- Necrosis
- Mitotic rate > 5/10 high power fields
- Tumor size > 5 cm
- Reference: Am J Surg Pathol 2005;29:143
Case reports
- 29 year old woman, previously diagnosed with polycystic ovarian syndrome, presented with complaints of amenorrhea for the past 3 years (Medicina (Kaunas) 2022;58:1638)
- 32 year old woman with rapidly growing pelvic tumors and widespread bulky peritoneal disseminations (Gynecol Oncol Rep 2018;24:54)
- 46 year old regularly menstruating woman presented with complaints of dull aching, recurrent pain in the suprapubic region (Clin Case Rep 2022;10:e05892)
Treatment
- Oophorectomy
- Chemotherapy with or without radiation if malignant
Gross description
- Unilateral, solid, tan to yellow
- Mean size is 8 cm
Frozen section description
- Frozen sections of ovarian tumors are common
- Frozen section will usually show a bland tumor composed of tubules
- History of hormone activity, unilaterality and young age are helpful features to recognize the tumor as likely benign
- Reference: Arch Pathol Lab Med 2019;143:47
Microscopic (histologic) description
- Tubular pattern (most common and usually present at least focally) with solid or hollow tubules
- Cuboidal or columnar cells
- Bland oval to round, monotonous nuclei
- Pale cytoplasm
- Lipid rich or oxyphilic variants may be associated with Peutz-Jeghers syndrome
- Other patterns: trabecular, diffuse, alveolar, pseudopapillary, reniform, pseudoendometrioid, spindled
- Absent to very rare Leydig cells
- Pathologic features predictive of malignant behavior include 5 mitoses per 10 high power fields, severe cytologic atypia, necrosis and size > 5 cm
- Reference: Am J Surg Pathol 2005;29:143
Microscopic (histologic) images
Positive stains
- Inhibin, SF1, calretinin
- Frequently positive: CD99, WT1, AE1 / AE3
- Reference: Am J Surg Pathol 2007;31:255
Negative stains
- EMA, CK7, PAX8, GATA3, chromogranin
Molecular / cytogenetics description
- DICER1 mutations can be seen in some of these tumors
Sample pathology report
- Ovary, right, oophorectomy:
- Sertoli cell tumor
Differential diagnosis
- Sertoli-Leydig cell tumor:
- Abundant Leydig cell component (MelanA positive)
- Endometrioid carcinoma:
- Carcinoid tumor:
- Associated teratoma or mucinous tumor
- Chromogranin positive
- Inhibin and SF1 negative
- Female adnexal tumor of probable Wolffian origin:
- Hilar Sertoli cell proliferation:
- Located in the hilum
- Microscopic
Additional references
Practice question #1
A 40 year old woman is seen in the clinic with complaints of irregular uterine bleeding and pelvic fullness. Transvaginal ultrasound shows a 9 cm right ovarian mass. The mass is surgically removed and a pathologic examination shows the features in the picture above. The mass is positive for inhibin and SF1. The tumor is negative for EMA, PAX8, MelanA and chromogranin. In which of the following general categories does this tumor belong?
- Epithelial
- Neuroendocrine tumor
- Pure sex cord tumor
- Sex cord stromal tumor
Practice answer #1
C. Pure sex cord tumor. Sertoli cell tumor is a pure sex cord neoplasm of the ovary composed of Sertoli cells most commonly arranged in a tubular pattern. Sertoli cells are positive for inhibin and SF1. Answer D is incorrect because no Leydig cells, which are positive for MelanA and are stromal in nature, are present. Answer B is incorrect because the tumor is negative for neuroendocrine markers. Answer A is incorrect because the tumor is negative for EMA and PAX8.
Comment Here
Reference: Sertoli cell tumor
Comment Here
Reference: Sertoli cell tumor